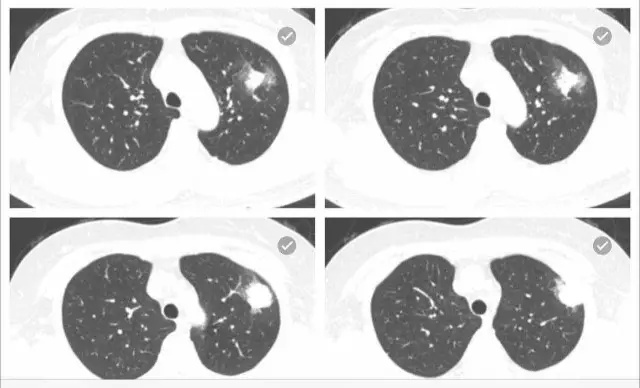

影像大讲堂|胸部平片和征象解读——贺文

——贺文
经典咨询
患者咳血胸痛一周。
肺部占位。
病变考虑为肿瘤或炎症,血象不高,肿瘤序列正常,结核试验阴性,ect阴性。请问贺主任意见?

贺文主任
贺文主任
左肺上叶尖段可见4.5*1.8cm的楔形实变病灶,尖端朝向肺门,周边可见浸润样实变。病灶中央可见低密度的无强化区,可见引流支气管;相邻胸膜可见增厚。会诊意见: 左肺上叶实变病灶,中央有液化坏死,考虑炎症性病变,霉菌、隐球菌或结核,请结合临床和治疗变化。供参考。建议最后提供原始轴位图像。
 和缓医生
和缓医生结核实验阴性,白细胞8000多,有咳血。
 贺文主任
贺文主任
病灶形态比较单一,不支持结核。但糖尿病患者结核可以有此表现。可以按照炎症治疗动态观察,三周。

没有糖尿病病史。谢谢贺教授,我们也诊断炎症,建议抗炎治疗两周后复查,胸外科考虑肿瘤,建议手术。

最好治疗观察。




胸部平片和征象解读—高KV胸片 VS 数字胸片
胸部平片和征象解读—解读胸片的两个基本原则
胸部平片和征象解读—胸片的几何学
胸部平片和征象解读—局部应用胸片影像
胸部平片和征象解读—影像的体征-征象
1. iPad观看方式:面向和缓用户
进入“和缓名医”App,进入“影像科”,点击顶部图片即可观看。

2. 微信观看2种方式:面向全体医师
(1) 长按以下二维码,一键观看授课视频。
(2) 或点击文章左下角“阅读原文”,一键观看授课视频。



